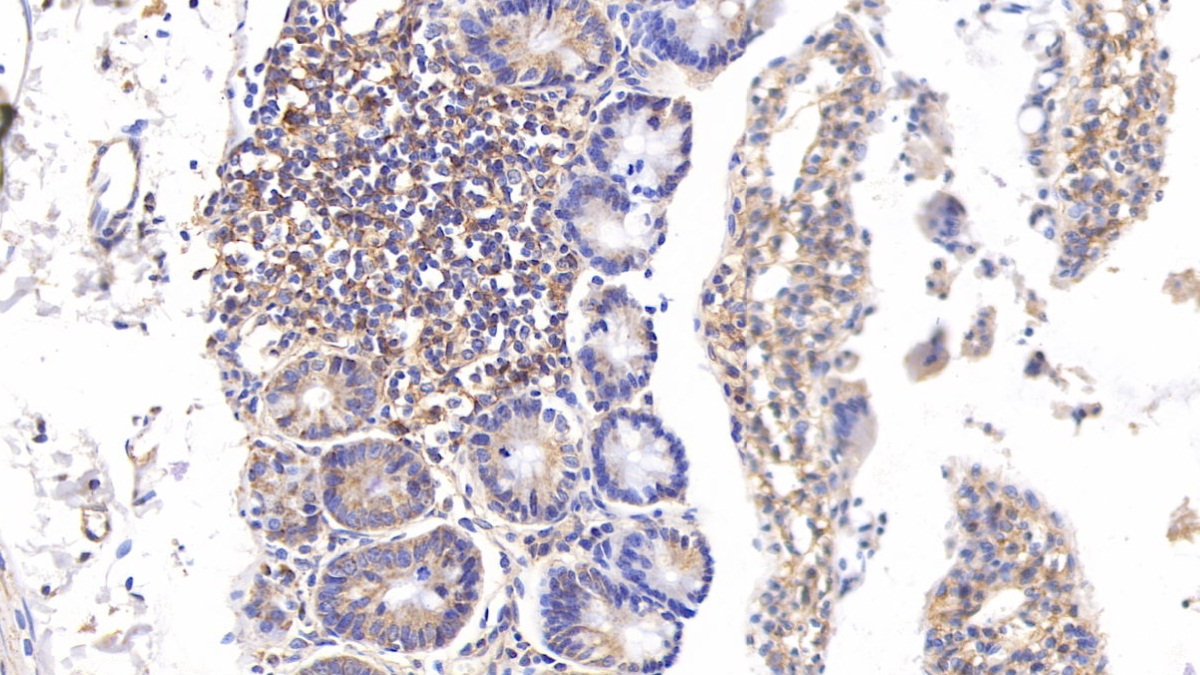

Polyclonal Antibody to Vascular Cell Adhesion Molecule 1 (VCAM1)
CD106; INCAM-100; L1CAM
- Product No.PAA547Ra02
- Organism SpeciesRattus norvegicus (Rat) Same name, Different species.
- SourcePolyclonal antibody preparation
- HostRabbit
- Potencyn/a
- Ig Type IgG
- PurificationAntigen-specific affinity chromatography followed by Protein A affinity chromatography
- LabelNone
- Immunogen RPA547Ra02-Recombinant Vascular Cell Adhesion Molecule 1 (VCAM1)
- Buffer Formulation0.01M PBS, pH7.4, containing 0.05% Proclin-300, 50% glycerol.
- TraitsLiquid
- Concentration500µg/mL
- Organism Species Moren/a
- ApplicationsWB; IHC
If the antibody is used in flow cytometry, please check FCM antibodies. - DownloadInstruction Manual
- UOM 20µl100µl 200µl 1ml 10ml
- FOB
US$ 103
US$ 239
US$ 342
US$ 855
US$ 3420
For more details, please contact local distributors!
SPECIFITY
The antibody is a rabbit polyclonal antibody raised against VCAM1. It has been selected for its ability to recognize VCAM1 in immunohistochemical staining and western blotting.
USAGE
Western blotting: 0.5-2µg/mL;
Immunohistochemistry: 5-20µg/mL;
Immunocytochemistry: 5-20µg/mL;
Optimal working dilutions must be determined by end user.
STORAGE
Store at 4°C for frequent use. Stored at -20°C in a manual defrost freezer for two year without detectable loss of activity. Avoid repeated freeze-thaw cycles.
STABILITY
The thermal stability is described by the loss rate. The loss rate was determined by accelerated thermal degradation test, that is, incubate the protein at 37°C for 48h, and no obvious degradation and precipitation were observed. The loss rate is less than 5% within the expiration date under appropriate storage condition.
GIVEAWAYS
INCREMENT SERVICES
-
 Antibody Labeling Customized Service
Antibody Labeling Customized Service
-
 Protein A/G Purification Column
Protein A/G Purification Column
-
 Staining Solution for Cells and Tissue
Staining Solution for Cells and Tissue
-
 Positive Control for Antibody
Positive Control for Antibody
-
 Tissue/Sections Customized Service
Tissue/Sections Customized Service
-
 Phosphorylated Antibody Customized Service
Phosphorylated Antibody Customized Service
-
 Western Blot (WB) Experiment Service
Western Blot (WB) Experiment Service
-
 Immunohistochemistry (IHC) Experiment Service
Immunohistochemistry (IHC) Experiment Service
-
 Immunocytochemistry (ICC) Experiment Service
Immunocytochemistry (ICC) Experiment Service
-
 Flow Cytometry (FCM) Experiment Service
Flow Cytometry (FCM) Experiment Service
-
 Immunoprecipitation (IP) Experiment Service
Immunoprecipitation (IP) Experiment Service
-
 Immunofluorescence (IF) Experiment Service
Immunofluorescence (IF) Experiment Service
-
 Buffer
Buffer
-
 DAB Chromogen Kit
DAB Chromogen Kit
-
 SABC Kit
SABC Kit
-
 Long-arm Biotin Labeling Kit
Long-arm Biotin Labeling Kit
-
 Real Time PCR Experimental Service
Real Time PCR Experimental Service
| Magazine | Citations |
| Amran et al. Lipids in Health and Disease | Changes in the vascular cell adhesion molecule-1, intercellular adhesion molecule-1 and c-reactive protein following administration of aqueous extract of piper sarmentosum on experimental. BioMed: 1476511X |
| Vascular Pharmacology | Long-term ethanol consumption initiates atherosclerosis in rat aorta through inflammatory stress and endothelial dysfunction ScienceDirect: S1537189112000705 |
| Canadian Journal of Physiology and Pharmacology | Resveratrol abrogates adhesion molecules and protects against TNBS-induced ulcerative colitis in rats. PubMed: 22029500 |
| British Journal of Medical and Health Sciences | EFFECTS OF ADRIAMYCIN, CISPLATIN, AND 5-FLUOROURACIL ON THE TESTES OF ALBINO RATS Researchgate: Source |
| Endocrine Metabolic & Immune Disordors Drug Targets. | Active immunization against tumor necrosis factor-alpha decreases proinflammatory cytokines, oxidative stress mediators and adhesion molecules risk factors in streptozotocin-induced diabetic rats. Pubmed: 23859636 |
| Atherosclerosis | Increased monocyte adhesion by endothelial expression of VCAM-1 missense variation in vitro Pubmed: 24075742 |
| Atherosclerosis | Activation of receptor for advanced glycation end products contributes to aortic remodeling and endothelial dysfunction in sinoaortic denervated rats. Pubmed: 23880178 |
| BioMed research international | Endothelial gene expression and molecular changes in response to radiosurgery in in vitro and in vivo models of cerebral arteriovenous malformations Pubmed: 24199192 |
| Arch Dis Child | PO-0699 Estimation Of Adhesion Molecules Intrauterine Growth Retardation (iugr) Newborns Bmj:Source |
| Arch Dis Child? | PO-0701 Causes Of Fetal Growth Restriction And Early Neonatal Outcome Bmj:Source |
| Arch Dis Child | PO-0698 Neonatal Resuscitation Practices In The Delivery Room In India: An Audit Using Videography Bmj:Source |
| Naunyn-Schmiedeberg's Archives of Pharmacology | Insights into the antiatherogenic molecular mechanisms of andrographolide against?Porphyromonas gingivalis-induced atherosclerosis in rabbits Pubmed:25172523 |
| Nutr Res. | Curcumin attenuates adhesion molecules and matrix metalloproteinase expression in hypercholesterolemic rabbits Pubmed:25282128 |
| Alexandria Journal of Medicine | Effect of consumption of fresh and heated virgin coconut oil on the blood pressure and inflammatory biomarkers: An experimental study in Sprague Dawley rats Sciencedirect:S2090506814000268 |
| Canadian Journal of Physiology and Pharmacology | Effect of magnesium sulfate and thyroxine on inflammatory markers in a rat model of hypothyroidism Doi: Abs |
| Hum Exp Toxicol | Effect of agmatine on experimental vascular endothelial dysfunction PubMed: 26424770 |
| International Journal of Food Sciences and Nutrition | Serum lipid profile and inflammatory markers in the aorta of cholesterol-fed rats supplemented with extra virgin olive oil, sunflower oils and oil-products PubMed: 26401576 |
| J Trace Elem Med Biol | Comparative angioprotective effects of magnesium compounds PubMed: 25127069 |
| J Mol Cell Cardiol | Diverse contribution of bone marrow-derived late-outgrowth endothelial progenitor cells to vascular repair under pulmonary arterial hypertension and arterial neointimal formation PubMed: 26231083 |
| Endocrine | Effects of glucagon-like peptide-1 on advanced glycation endproduct-induced aortic endothelial dysfunction in streptozotocin-induced diabetic rats: possible roles of Rho kinase- and AMP kinase-mediated nuclear factor κB signaling pathways Pubmed:26758998 |
| Mol Neurobiol | A Therapeutic Insight of Niacin and Coenzyme Q10 Against Diabetic Encephalopathy in Rats Pubmed:26867655 |
| Pakistan journal of pharmaceutical sciences | Changes in blood pressure, vascular reactivity and inflammatory biomarkers following consumption of heated corn oil. pubmed:29084680 |
| Acta Biochim Biophys Sin | Therapeutic potential of mesenchymal stem cells in acute kidney injury is affected by administration timing pubmed:28338909 |
| Experimental and Therapeutic Medicine | Epigallocatechin‑3‑gallate attenuates neointimal hyperplasia in a rat model of carotid artery injury by inhibition of high mobility group box 1 expression pubmed:28962112 |
| Experimental Parasitology | Adhesion molecules, chemokines and matrix metallo-proteinases response after albendazole and albendazole plus steroid therapy in swine neurocysticercosis pubmed:28821422 |
| Evidence-Based Complementary and Alternative Medicine | BuShenKangShuai tablet reduces atherosclerotic lesion by improving blood lipids metabolism and inhibiting inflammatory response via TLR4 and NF-κB signaling pathway journals:1758383 |
| Journal of Chromatography A | Application of a new procedure for liquid chromatography/mass spectrometry profiling of plasma amino acid-related metabolites and untargeted shotgun proteomics to identify mechanisms and biomarkers of calcific aortic stenosis S0021967317311858 |
| International Journal of Clinical and Experimental Pathology | Protective effect of high mobility group box-1 silence on diabetic retinopathy: an in vivo study ISSN:1936-2625/IJCEP0055881 |
| ResearchGate | Significance of Soluble Endoglin as a Possible Marker of Cardiovascular Disease in Type 2 Diabetic Patients 315113405 |
| Regenerative Biomaterials | The directional migration and differentiation of mesenchymal stem cells toward vascular endothelial cells stimulated by biphasic calcium phosphate ceramic 10.1093/rb/rbx028 |
| Anesthesiology | Vasculotide, an angiopoietin-1 mimetic, restores microcirculatory perfusion and microvascular leakage and decreases fluid resuscitation requirements in … Pubmed:28968277 |
| PLoS Neglected Tropical Diseases | Characterization of the rhesus macaque (Macaca mulatta) scrub typhus model: Susceptibility to intradermal challenge with the human pathogen Orientia … Pubmed:29522521 |
| Life Sciences | Nephroprotective effect of saxagliptin against gentamicin-induced nephrotoxicity, emphasis on anti-oxidant, anti-inflammatory and anti-apoptic effects Pubmed:30012474 |
| Evidence-based Complementary and Alternative Medicine | Bushenkangshuai Tablet Reduces Atherosclerotic Lesion by Improving Blood Lipids Metabolism and Inhibiting Inflammatory Response via TLR4 and NF-κB Signaling … Pubmed:29619063 |
| Nutrition & Metabolism | L-Carnitine Supplementation Increases Trimethylamine-N-Oxide but not Markers of Atherosclerosis in Healthy Aged Women Pubmed: 30485835 |
| Cytokine | Intercellular adhesion molecule-1 (ICAM-1) associates with 24-hour ambulatory blood pressure variability in type 2 diabetes and controls Pubmed: 30716657 |
| Anticancer Research | Effect of Radiation on the Expression of CVD-related miRNAs, Inflammation and Endothelial Dysfunction of HUVECs Pubmed: 30711956 |
| European Journal of Pharmacology | The cordycepin derivative IMM-H007 improves endothelial dysfunction by suppressing vascular inflammation and promoting AMPK-dependent eNOS activation in … Pubmed: 30826323 |
| international journal of molecular sciences | Anti-Inflammatory and Anti-Apoptotic Effects of Stybenpropol A on Human Umbilical Vein Endothelial Cells Pubmed: 31671764 |
| Archives of Insect Biochemistry and Physiology | Vanadyl sulphate ameliorates biomarkers of endothelial injury and coagulation and thrombosis in a rat model of hyperglycaemia Pubmed: 31774317 |
| BMC Endocrine Disorders | The role of the adipocytokines vaspin and visfatin in vascular endothelial function and insulin resistance in obese children Pubmed: 31771561 |
| Scientific Reports | Association between Upper-airway Surgery and Ameliorative Risk Markers of endothelial function in obstructive Sleep Apnea Pubmed: 31882827 |
| BIOCHIMICA ET BIOPHYSICA ACTA-MOLECULAR BASIS OF DISEASE | Endothelial epithelial sodium channel involves in high-fat diet-induced atherosclerosis in low-density lipoprotein receptor-deficient mice Pubmed: 33065235 |
| Antioxidants (Basel) | Anti-Atherogenic Effects of Orlistat on Obesity-Induced Vascular Oxidative Stress Rat Model 33562069 |
| Sci. Pharm | Dehydroepiandrosterone (DHEA) Improves the Metabolic and Haemostatic Disturbances in Rats with Male Hypogonadism |
| Journal of the South African Veterinary Association | Circulating markers of endothelial activation in canine parvoviral enteritis |